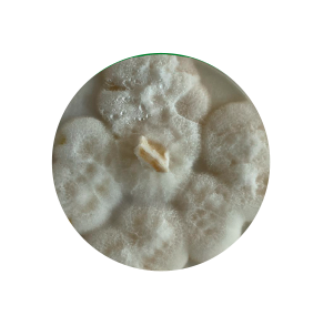
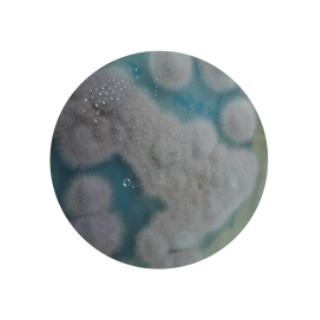

BLEND NEMA
Ex.: Meloidogyne / Pratylenchus / Cisto
▶ Vídeo do blend NEMA
 Trichoderma spp.
Trichoderma spp.
- Antagonismo e competição; parasita estruturas reprodutivas.
- Enzimas/metabólitos que degradam ovos/juvenis.
Pochonia chlamydosporia
Pochonia chlamydosporia
- Parasitismo de ovos — redução populacional.
Paecilomyces lilacinus
Paecilomyces lilacinus
- Ataque a ovos e fêmeas; toxinas impedem desenvolvimento.
